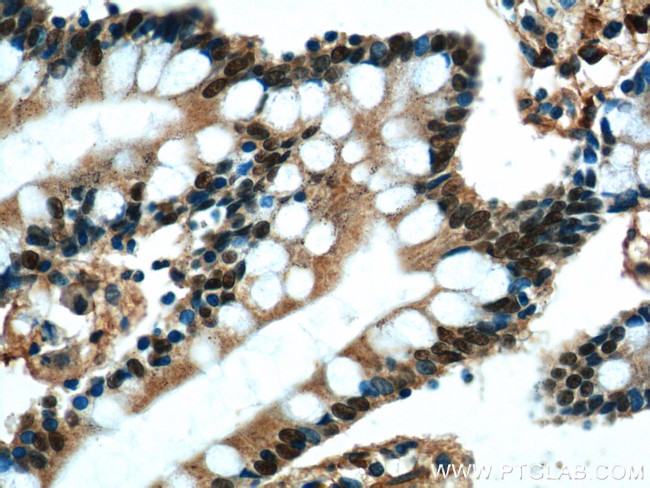
HNF4G Antibody in Immunohistochemistry (Paraffin) (IHC (P))

Search
Proteintech
HNF4G Polyclonal Antibody
{{$productOrderCtrl.translations['antibody.pdp.commerceCard.promotion.promotions']}}
{{$productOrderCtrl.translations['antibody.pdp.commerceCard.promotion.viewpromo']}}
{{$productOrderCtrl.translations['antibody.pdp.commerceCard.promotion.promocode']}}: {{promo.promoCode}} {{promo.promoTitle}} {{promo.promoDescription}}. {{$productOrderCtrl.translations['antibody.pdp.commerceCard.promotion.learnmore']}}
产品信息
25801-1-AP
种属反应
已发表种属
宿主/亚型
分类
类型
抗原
偶联物
形式
浓度
规格
纯化类型
保存液
内含物
保存条件
运输条件
产品详细信息
This polyclonal antibody is raised against C-terminal 82 amino acids of human HNF4-gamma.
Immunogen sequence: GGASNDGSH LHHPMHPHLS QDPLTGQTIL LGPMSTLVHA DQISTPETPL PSPPQGSGQE QYKIAANQAS VISHQHLSKQ KQL (327-408 aa encoded by BC105009)
靶标信息
HNF4G is a transcription factor. It has a lower transcription activation potential than HNF4-alpha.
仅用于科研。不用于诊断过程。未经明确授权不得转售。
生物信息学
蛋白别名: Hepatocyte nuclear factor 4-gamma; HNF-4 gamma; HNF-4-gamma; HNF4 gamma; HNF4-beta; HNF4G; Hnf4gamma; Nuclear receptor subfamily 2 group A member 2
基因别名: HNF4G; NR2A2; NR2A3
UniProt ID: (Human) Q14541, (Mouse) Q9WUU6
Entrez Gene ID: (Human) 3174, (Mouse) 30942